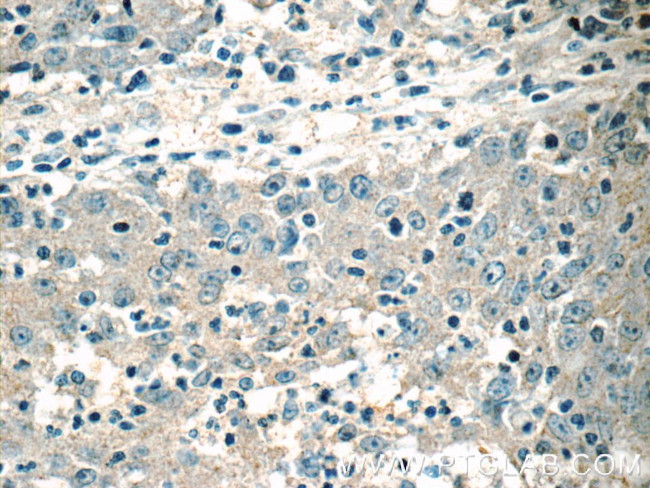
HSCB Antibody in Immunohistochemistry (Paraffin) (IHC (P))

Search
Proteintech
HSCB Polyclonal Antibody
{{$productOrderCtrl.translations['antibody.pdp.commerceCard.promotion.promotions']}}
{{$productOrderCtrl.translations['antibody.pdp.commerceCard.promotion.viewpromo']}}
{{$productOrderCtrl.translations['antibody.pdp.commerceCard.promotion.promocode']}}: {{promo.promoCode}} {{promo.promoTitle}} {{promo.promoDescription}}. {{$productOrderCtrl.translations['antibody.pdp.commerceCard.promotion.learnmore']}}
产品信息
15132-1-AP
种属反应
宿主/亚型
分类
类型
抗原
偶联物
形式
浓度
规格
纯化类型
保存液
内含物
保存条件
运输条件
产品详细信息
Immunogen sequence: MWRGRAGAL LRVWGFWPTG VPRRRPLSCD AASQAGSNYP RCWNCGGPWG PGREDRFFCP QCRALQAPDP TRDYFSLMDC NRSFRVDTAK LQHRYQQLQR LVHPDFFSQR SQTEKDFSEK HSTLVNDAYK TLLAPLSRGL YLLKLHGIEI PERTDYEMDR QFLIEIMEIN EKLAEAESEA AMKEIESIVK AKQKEFTDNV SSAFEQDDFE EAKEILTKMR YFSNIEEKIK LKKIPL (1-235 aa encoded by B C065569)
靶标信息
May act as a co-chaperone in iron-sulfur cluster assembly in mitochondria.
仅用于科研。不用于诊断过程。未经明确授权不得转售。
生物信息学
蛋白别名: dJ366L4.2; DnaJ (Hsp40) homolog, subfamily C, member 20; DnaJ homolog subfamily C member 20; epididymis secretory sperm binding protein; HscB iron-sulfur cluster co-chaperone homolog; HscB mitochondrial iron-sulfur cluster co-chaperone; Iron-sulfur cluster co-chaperone protein HscB; iron-sulfur cluster co-chaperone protein HscB, mitochondrial; J-type co-chaperone HSC20
基因别名: DNAJC20; HSC20; HSCB; JAC1; RGD1311005; SIDBA5
UniProt ID: (Human) Q8IWL3
Entrez Gene ID: (Human) 150274, (Rat) 360826